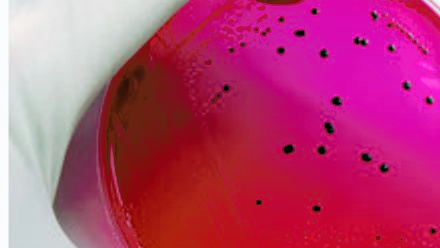
MT Aug 2013 Petri dish

Biogeography
2013 marked the 100th anniversary of the death of Alfred R. Wallace, well known amongst biologists and perhaps the wider public for being the co-discoverer of natural selection as the mechanism for evolution of new species. What may not be as widely known is Wallace's work on the geographical distribution of animals and plants, and that he is viewed by many as the father of biogeography. This magazine explores his work and its application in the field of microbiology.